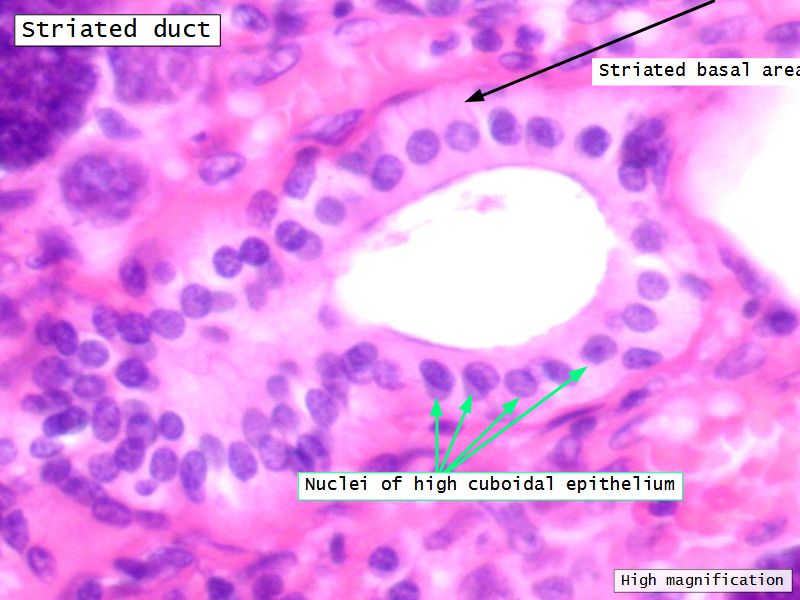

Oral Cavity

- esc key shows all the slides
- arrows left right advance the slide
- or click on the bottom right icons
- mobile device swipe left right
- ? gives instant help
- Have a pen & paper ready
- Answer every question
- Mark your answer after answering
- Elaborate on each answer
- Add relevant clinical content
- If you have trouble, ask

The End
Save Document
- Click the link above
- Print to PDF
Works best using Google Chrome
Others Browser YMMV